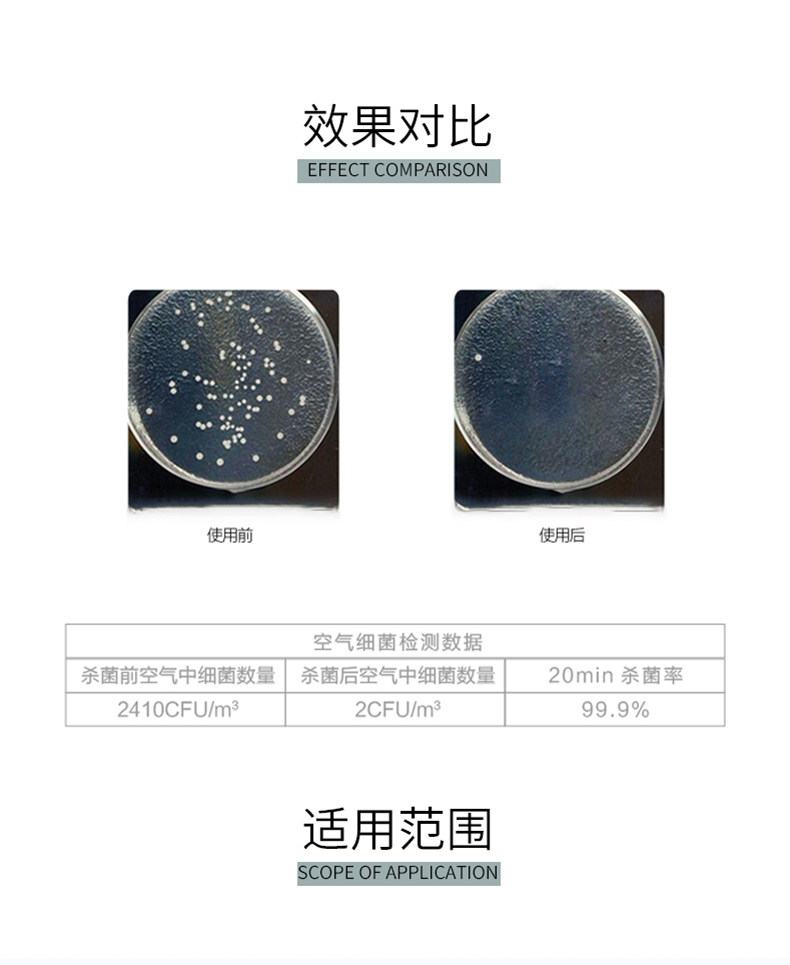

Mootaa/膜太 Дезинфицирующий спрей, антибактериальный аэрозоль для домашнего использования, не вызывает раздражения

Цена: 1 036руб. (¥49)
Артикул: 618701625012
Цена указана со скидкой: 58%
Старая цена: 2452р.
Вес товара: ~0.7 кг. Указан усредненный вес, который может отличаться от фактического. Не включен в цену, оплачивается при получении.
Описание товараPGRpdj48aW1nIHNyYz0iaHR0cHM6Ly9pbWcuYWxpY2RuLmNvbS9pbWdleHRyYS9pNC8zNTk2NjUxNzQ4L08xQ04wMU1BYkVJVzFPbWN1WmUwenB3XyEhMzU5NjY1MTc0OC0wLXNjbWl0ZW0xMDAwLmpwZyI+PC9kaXY+PGRpdj48aW1nIHNyYz0iaHR0cHM6Ly9pbWcuYWxpY2RuLmNvbS9pbWdleHRyYS9pNC8zNTk2NjUxNzQ4L08xQ04wMVoyQlk5czFPbWN1WjVvZ3BRXyEhMzU5NjY1MTc0OC0wLXNjbWl0ZW0xMDAwLmpwZyI+PC9kaXY+PGRpdj48aW1nIHNyYz0iaHR0cHM6Ly9pbWcuYWxpY2RuLmNvbS9pbWdleHRyYS9pNC8zNTk2NjUxNzQ4L08xQ04wMXF1Q1o0MTFPbWN1WFJYRU9CXyEhMzU5NjY1MTc0OC0wLXNjbWl0ZW0xMDAwLmpwZyI+PC9kaXY+PGRpdj48aW1nIHNyYz0iaHR0cHM6Ly9pbWcuYWxpY2RuLmNvbS9pbWdleHRyYS9pMi8zNTk2NjUxNzQ4L08xQ04wMVAzb0k4YTFPbWN1Vmp3NExOXyEhMzU5NjY1MTc0OC0wLXNjbWl0ZW0xMDAwLmpwZyI+PC9kaXY+PGRpdj48aW1nIHNyYz0iaHR0cHM6Ly9pbWcuYWxpY2RuLmNvbS9pbWdleHRyYS9pMi8zNTk2NjUxNzQ4L08xQ04wMVJ2eVpaVTFPbWN1VUZTQkdVXyEhMzU5NjY1MTc0OC0wLXNjbWl0ZW0xMDAwLmpwZyI+PC9kaXY+PGRpdj48aW1nIHNyYz0iaHR0cHM6Ly9pbWcuYWxpY2RuLmNvbS9pbWdleHRyYS9pMS8zNTk2NjUxNzQ4L08xQ04wMThPelNCMzFPbWN1V0JzT3VOXyEhMzU5NjY1MTc0OC0wLXNjbWl0ZW0xMDAwLmpwZyI+PC9kaXY+PGRpdj48aW1nIHNyYz0iaHR0cHM6Ly9pbWcuYWxpY2RuLmNvbS9pbWdleHRyYS9pMS8zNTk2NjUxNzQ4L08xQ04wMVFGMzN2MDFPbWN1WjVvZ3FHXyEhMzU5NjY1MTc0OC0wLXNjbWl0ZW0xMDAwLmpwZyI+PC9kaXY+PGRpdj48aW1nIHNyYz0iaHR0cHM6Ly9pbWcuYWxpY2RuLmNvbS9pbWdleHRyYS9pMS8zNTk2NjUxNzQ4L08xQ04wMWJ2bEgxejFPbWN1U3hZU2Y4XyEhMzU5NjY1MTc0OC0wLXNjbWl0ZW0xMDAwLmpwZyI+PC9kaXY+PGRpdj48aW1nIHNyYz0iaHR0cHM6Ly9pbWcuYWxpY2RuLmNvbS9pbWdleHRyYS9pNC8zNTk2NjUxNzQ4L08xQ04wMWhKVWZ6YjFPbWN1U3hZV3BEXyEhMzU5NjY1MTc0OC0wLXNjbWl0ZW0xMDAwLmpwZyI+PC9kaXY+PGRpdj48aW1nIHNyYz0iaHR0cHM6Ly9pbWcuYWxpY2RuLmNvbS9pbWdleHRyYS9pNC8zNTk2NjUxNzQ4L08xQ04wMVpkQkVHRzFPbWN1V1hTallpXyEhMzU5NjY1MTc0OC0wLXNjbWl0ZW0xMDAwLmpwZyI+PC9kaXY+PGRpdj48aW1nIHNyYz0iaHR0cHM6Ly9pbWcuYWxpY2RuLmNvbS9pbWdleHRyYS9pMy8zNTk2NjUxNzQ4L08xQ04wMVBEWlJxRDFPbWN1WFJZdUt4XyEhMzU5NjY1MTc0OC0wLXNjbWl0ZW0xMDAwLmpwZyI+PC9kaXY+PGRpdj48aW1nIHNyYz0iaHR0cHM6Ly9pbWcuYWxpY2RuLmNvbS9pbWdleHRyYS9pMi8zNTk2NjUxNzQ4L08xQ04wMWpZNmxtNjFPbWN1VHVscUtCXyEhMzU5NjY1MTc0OC0wLXNjbWl0ZW0xMDAwLmpwZyI+PC9kaXY+PGRpdj48aW1nIHNyYz0iaHR0cHM6Ly9pbWcuYWxpY2RuLmNvbS9pbWdleHRyYS9pNC8zNTk2NjUxNzQ4L08xQ04wMUlxUjBaMTFPbWN1U3hYemFFXyEhMzU5NjY1MTc0OC0wLXNjbWl0ZW0xMDAwLmpwZyI+PC9kaXY+PGRpdj48aW1nIHNyYz0iaHR0cHM6Ly9pbWcuYWxpY2RuLmNvbS9pbWdleHRyYS9pMS8zNTk2NjUxNzQ4L08xQ04wMUt1UUNGaTFPbWN1VHVtSlJiXyEhMzU5NjY1MTc0OC0wLXNjbWl0ZW0xMDAwLmpwZyI+PC9kaXY+PGRpdj48aW1nIHNyYz0iaHR0cHM6Ly9pbWcuYWxpY2RuLmNvbS9pbWdleHRyYS9pMi8zNTk2NjUxNzQ4L08xQ04wMTA5MWpGZzFPbWN1YWg2V0o1XyEhMzU5NjY1MTc0OC0wLXNjbWl0ZW0xMDAwLmpwZyI+PC9kaXY+PGRpdj48aW1nIHNyYz0iaHR0cHM6Ly9pbWcuYWxpY2RuLmNvbS9pbWdleHRyYS9pMi8zNTk2NjUxNzQ4L08xQ04wMTdXWGR5WTFPbWN1VzJUd3NsXyEhMzU5NjY1MTc0OC0wLXNjbWl0ZW0xMDAwLmpwZyI+PC9kaXY+PGRpdj48aW1nIHNyYz0iaHR0cHM6Ly9pbWcuYWxpY2RuLmNvbS9pbWdleHRyYS9pMS8zNTk2NjUxNzQ4L08xQ04wMTlLUGZCUzFPbWN1WUpBQ2JYXyEhMzU5NjY1MTc0OC0wLXNjbWl0ZW0xMDAwLmpwZyI+PC9kaXY+PGRpdj48aW1nIHNyYz0iaHR0cHM6Ly9pbWcuYWxpY2RuLmNvbS9pbWdleHRyYS9pNC8zNTk2NjUxNzQ4L08xQ04wMU5LOW5XTzFPbWN1VHVtejFEXyEhMzU5NjY1MTc0OC0wLXNjbWl0ZW0xMDAwLmpwZyI+PC9kaXY+PGRpdj48aW1nIHNyYz0iaHR0cHM6Ly9pbWcuYWxpY2RuLmNvbS9pbWdleHRyYS9pMi8zNTk2NjUxNzQ4L08xQ04wMXByZWRndDFPbWN1V2FSTU45XyEhMzU5NjY1MTc0OC0wLXNjbWl0ZW0xMDAwLmpwZyI+PC9kaXY+PGRpdj48aW1nIHNyYz0iaHR0cHM6Ly9pbWcuYWxpY2RuLmNvbS9pbWdleHRyYS9pMy8zNTk2NjUxNzQ4L08xQ04wMWtZNUdlcDFPbWN1VzJUUGVKXyEhMzU5NjY1MTc0OC0wLXNjbWl0ZW0xMDAwLmpwZyI+PC9kaXY+PGRpdj48aW1nIHNyYz0iaHR0cHM6Ly9pbWcuYWxpY2RuLmNvbS9pbWdleHRyYS9pMi8zNTk2NjUxNzQ4L08xQ04wMXV5TWJ6QzFPbWN1WmR6bjU3XyEhMzU5NjY1MTc0OC0wLXNjbWl0ZW0xMDAwLmpwZyI+PC9kaXY+PGRpdj48aW1nIHNyYz0iaHR0cHM6Ly9pbWcuYWxpY2RuLmNvbS9pbWdleHRyYS9pMi8zNTk2NjUxNzQ4L08xQ04wMXYzUDVvQzFPbWN1WmUyOFlvXyEhMzU5NjY1MTc0OC0wLXNjbWl0ZW0xMDAwLmpwZyI+PC9kaXY+PGRpdj48aW1nIHNyYz0iaHR0cHM6Ly9pbWcuYWxpY2RuLmNvbS9pbWdleHRyYS9pMi8zNTk2NjUxNzQ4L08xQ04wMWpIVlRscDFPbWN1Vmp3TDFYXyEhMzU5NjY1MTc0OC0wLXNjbWl0ZW0xMDAwLmpwZyI+PC9kaXY+PGRpdj48aW1nIHNyYz0iaHR0cHM6Ly9pbWcuYWxpY2RuLmNvbS9pbWdleHRyYS9pMS8zNTk2NjUxNzQ4L08xQ04wMWdUanVETjFPbWN1YUpNM1VLXyEhMzU5NjY1MTc0OC0wLXNjbWl0ZW0xMDAwLmpwZyI+PC9kaXY+PGRpdj48aW1nIHNyYz0iaHR0cHM6Ly9pbWcuYWxpY2RuLmNvbS9pbWdleHRyYS9pMy8zNTk2NjUxNzQ4L08xQ04wMWNrcGlKZjFPbWN1T0g5Z21XXyEhMzU5NjY1MTc0OC0wLXNjbWl0ZW0xMDAwLmpwZyI+PC9kaXY+PGRpdj48aW1nIHNyYz0iaHR0cHM6Ly9pbWcuYWxpY2RuLmNvbS9pbWdleHRyYS9pMS8zNTk2NjUxNzQ4L08xQ04wMU5BOHNZUjFPbWN1T0g3MFZBXyEhMzU5NjY1MTc0OC0wLXNjbWl0ZW0xMDAwLmpwZyI+PC9kaXY+PGRpdj48aW1nIHNyYz0iaHR0cHM6Ly9pbWcuYWxpY2RuLmNvbS9pbWdleHRyYS9pNC8zNTk2NjUxNzQ4L08xQ04wMTBOY2w0bDFPbWN1V0J1YzVVXyEhMzU5NjY1MTc0OC0wLXNjbWl0ZW0xMDAwLmpwZyI+PC9kaXY+
Продавец:天猫国际小酒馆
Адрес:Шанхай
Рейтинг:

Всего отзывов:0
Положительных:0
Добавить в корзину
- Информация о товаре
- Фотографии